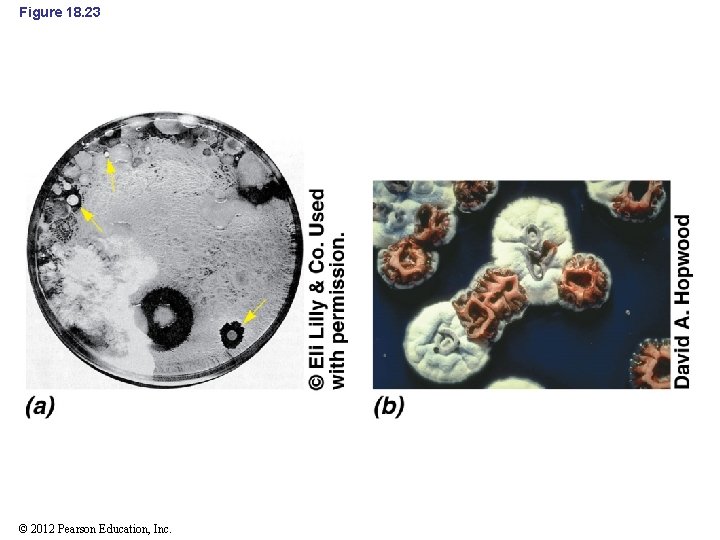
Figure 18. 23 © 2012 Pearson Education, Inc.

Overview of GramPositive and Other Bacteria Bacteria has

Overview of Gram-Positive and Other Bacteria • Bacteria has many phyla other than Proteobacteria, including – Gram-positive bacteria • Large group of mostly chemoorganotrophs – Cyanobacteria • Oxygenic phototrophs that have evolutionary roots near those of gram-positive bacteria – Phylogenetically early-branching phyla • Such as Aquifex – Other morphologically distinct groups © 2012 Pearson Education, Inc.

I. Firmicutes, Mollicutes, and Actinobacteria • Gram-positive bacteria are a large and diverse group • Divided into three groups: – Firmicutes – Mollicutes – Actinobacteria © 2012 Pearson Education, Inc.

18. 1 Nonsporulating Firmicutes • Key genera: Staphylococcus, Streptococcus, Lactobacillus, Sarcina • Staphylococcus and Micrococcus (Figure 18. 1) – Aerobic, cocci – Resistant to reduced water potential – Tolerate high salt – Many species are pigmented – Staphylococcus aureus © 2012 Pearson Education, Inc.

Figure 18. 1 © 2012 Pearson Education, Inc.

18. 1 Nonsporulating Firmicutes • Streptococcus – Play important roles in production of buttermilk, silage, and other products – Some species are pathogenic – Lactococcus: genera of dairy significance (Figure 18. 3) – Enterococcus: genera of fecal origin © 2012 Pearson Education, Inc.

Figure 18. 3 © 2012 Pearson Education, Inc.

18. 2 Endospore-Forming Firmicutes • Key genera: Bacillus & Clostridium – Distinguished on the basis of cell morphology, and the shape and cellular position of endospore – Generally found in soils – Endospores are advantageous for soil microorganisms © 2012 Pearson Education, Inc.

Figure 18. 5 © 2012 Pearson Education, Inc.

18. 2 Endospore-Forming Firmicutes • Bacillus – Many produce extracellular hydrolytic enzymes that break down polymers – Many bacilli produce antibiotics – Bacillus thuringiensis produces insect larvicides (Figure 18. 6) © 2012 Pearson Education, Inc.

Figure 18. 6 Endospore © 2012 Pearson Education, Inc. Crystal

18. 2 Endospore-Forming Firmicutes • Clostridium – Lack a respiratory chain, anaerobic – Mainly found in anaerobic pockets in the soil • Also live in mammalian intestinal tract – Some cause diseases such as botulism, tetanus, and gangrene © 2012 Pearson Education, Inc.

18. 3 Mollicutes: The Mycoplasmas • Key genera: Mycoplasma – Lack cell walls – Some of the smallest organisms capable of autonomous growth – Parasites that inhabit animal and plant hosts – Key components of peptidoglycan are missing • Mycoplasma cells are pleomorphic – Cells may be cocci or filaments of various lengths © 2012 Pearson Education, Inc.

Figure 18. 9 © 2012 Pearson Education, Inc.

18. 4 Actinobacteria: Coryneform & Mycobacteria • Key genera: Corynebacterium & Mycobacterium – – Actinobacteria form their own phylum Over 30 taxonomic families Rod-shaped to filamentous, usually aerobic Mostly harmless commensals (Mycobacterium are exceptions) – Valuable for antibiotics and certain fermented dairy products © 2012 Pearson Education, Inc.

18. 4 Actinobacteria: Coryneform & Propionic Acid Bacteria • Corynebacterium – Gram-positive, aerobic, nonmotile, rod-shaped – Form club-shaped, irregular-shaped, or V-shaped cell arrangements – Extremely diverse © 2012 Pearson Education, Inc.

Figure 18. 12 © 2012 Pearson Education, Inc.

18. 5 Actinobacteria: Mycobacterium • Mycobacterium – Rod-shaped organisms, exhibit acid-fastness (Figure 18. 15) – First discovered by Robert Koch – Not readily stained by Gram stain because of high surface lipid content © 2012 Pearson Education, Inc.

Figure 18. 16 © 2012 Pearson Education, Inc.

18. 6 Filamentous Actinobacteria: Streptomyces & Relatives • Key genera: Streptomyces, Actinomyces (Figure 18. 18) – Filamentous, gram-positive bacteria – Produce mycelium analogous to mycelium of fungi – Over 500 species of Streptomyces – Streptomyces spores are called conidia (Figure 18. 19) – Primarily soil microorganisms, responsible for earthy odor of soil (geosmins) – Strict aerobes that produce many extracellular enzymes © 2012 Pearson Education, Inc.

Figure 18. 18 © 2012 Pearson Education, Inc.

18. 6 Filamentous Actinobacteria: Streptomyces & Relatives • Streptomyces (Figure 18. 22) – 50% of all isolated Streptomyces produce antibiotics (Figure 18. 23) – Over 500 distinct antibiotics produced by Streptomyces – Some produce more than one antibiotic – Genomes are typically quite large (8 Mbp and larger) – Knowledge of the ecology of Streptomyces remains poor © 2012 Pearson Education, Inc.

Figure 18. 22 © 2012 Pearson Education, Inc.
Figure 18. 23 © 2012 Pearson Education, Inc.

18. 7 Cyanobacteria • Phototrophic • Gas vesicles are found in many cyanobacteria – Help maintain buoyancy – Keep cell in water column where there is light • Heterocysts are rounded, enlarged cells – Anoxic environment inside heterocyst – Site for nitrogen fixation – Nitrogenase is sensitive to oxygen © 2012 Pearson Education, Inc.

Figure 18. 24 © 2012 Pearson Education, Inc.

Figure 18. 26 Heterocyst Glutamine Heterocyst Vegetative cells © 2012 Pearson Education, Inc. Vegetative cells

18. 9 The Chlamydia • Key genera: Chlamydia • Obligately parasitic with poor metabolic capacities – Some of the simplest biochemical capacities of all known bacteria • Currently one of the leading sexually transmitted diseases © 2012 Pearson Education, Inc.

Figure 18. 30 © 2012 Pearson Education, Inc.

Figure 18. 31 Release of elementary bodies Conversion to elementary bodies Elementary body attacks host cell Phagocytosis of elementary body Reticulate body Multiplication of reticulate bodies Conversion to reticulate body © 2012 Pearson Education, Inc. Elementary bodies

18. 10 Planctomyces: A Phylogenetically Unique Bacterium • Key genera: Planctomyces • Planctomyces is a budding bacterium – – Facultative aerobic chemoorganotroph Stalked Primarily aquatic Extensive cell compartmentalization including a membrane-enclosed nuclear structure © 2012 Pearson Education, Inc.

Figure 18. 32 Flagellum Pilus Stalk © 2012 Pearson Education, Inc. Stalk

Figure 18. 33 Nucleoid Nuclear envelope © 2012 Pearson Education, Inc.

Bacteroides • Key genera: • Bacteroides – Obligately anaerobic – Numerically dominant bacterium in human intestinal tract © 2012 Pearson Education, Inc.

18. 15 Chlorobium and Other Green Sulfur Bacteria • Key genera: Chlorobium – Phylogenetically distinct, nonmotile, anoxygenic phototrophs – Utilize H 2 S as an electron donor and oxidize it to SO 42 – Have chlorosomes bacteriochlorophyll-rich bodies bounded by a thin membrane – Green- and brown-colored species exist © 2012 Pearson Education, Inc.

Figure 18. 39 © 2012 Pearson Education, Inc.

18. 15 Chlorobium and Other Green Sulfur Bacteria • Green sulfur bacteria inhabit anoxic environments rich in H 2 S • Some green sulfur bacteria form consortia – Involves the green sulfur bacterium and a chemoorganotrophic bacterium © 2012 Pearson Education, Inc.

18. 16 Spirochetes • Key genera: Spirochaeta, Treponema, Leptospira, Borrelia – Gram-negative, motile, and coiled – Widespread in aquatic environments and in animals – Have endoflagella: located in the periplasm of the cell – Also found in the rumen of animals © 2012 Pearson Education, Inc.

Figure 18. 42 © 2012 Pearson Education, Inc.

Figure 18. 43 Endoflagellum (rigid, rotates, attached to one end of protoplasmic cylinder) Endoflagellum Outer sheath (flexible) Protoplasmic cylinder Outer sheath Protoplasmic cylinder (rigid, generally helical) © 2012 Pearson Education, Inc.

18. 16 Spirochetes • Spirochaeta – Free-living, anaerobic and facultatively anaerobic spirochetes • Treponema (Figure 18. 45 a) – Anaerobic host-associated spirochetes that are commensal or parasites of humans • Borrelia (Figure 18. 45 b) – Majority are human or animal pathogens – Borrelia burgdorferi is the causative agent of Lyme disease • B. burgdorferi has a linear chromosome © 2012 Pearson Education, Inc.

Deinococcus • Deinococcus – Gram-positive, aerobic, organotrophic – Most are red or pink due to carotenoids – Resist UV radiation, gamma radiation, and desiccation – Resistant to most mutagenic agents © 2012 Pearson Education, Inc.

18. 20 Aquifex • Key genera: Aquifex – Aquifex • Obligately chemolithotrophic hyperthermophile • Most thermophilic of all Bacteria (can grow at 95 C) • 1. 55 -Mbp genome © 2012 Pearson Education, Inc.
- Slides: 42